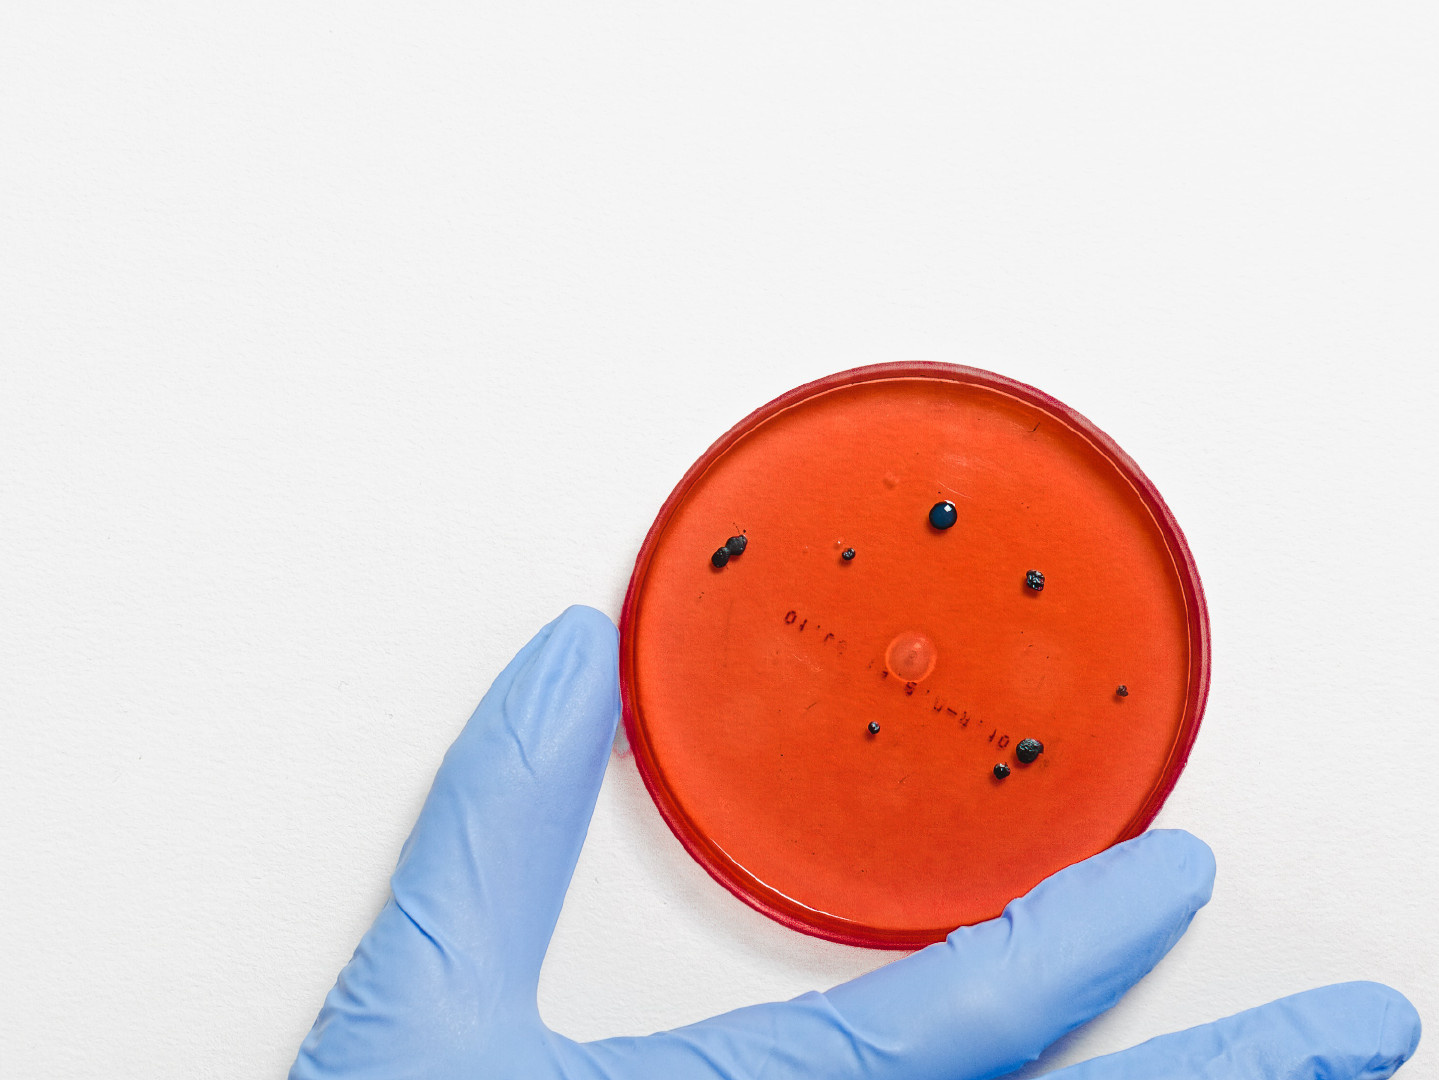

Corona legt derzeit die Fundraising-Arbeit im Bistum lahm: Aktionen werden zurückgestellt und persönliche Treffen der Projektgruppen entfallen. Die Zeit kann aber genutzt werden, um zu analysieren und vorauszudenken. Deshalb bietet die Stabsstelle Fundraising zusätzliche Möglichkeiten der Beratung per Telefon, Mail oder Chat an. Schreiben Sie uns eine Mail, und wir vereinbaren zeitnah die nächsten Schritte. Auch die Kommunikation per Facebook wird intensiviert. Darüber hinaus versorgen wir die bestehenden Projektgruppen mit zusätzlichen digitalen Impulsen.